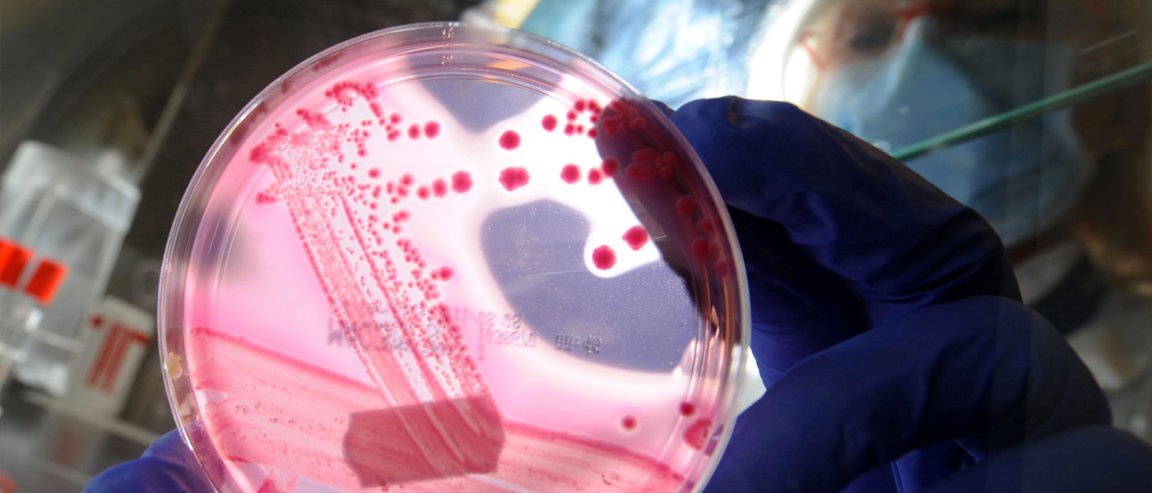

You Weigh 2% Bacteria
Scientists are looking into the “motherload” of drug sources for human diseases: our own guts.
Around two percent of our body weight is from the bacteria in our body, more than 130 species in the gut alone. Probiotics have been proven to affect our overall health. Imbalances in our gut microbiome, or the population of those microbes in our gut, contribute to complex conditions like obesity, inflammatory bowel disease, irritable bowel syndrome, and allergies.
Researchers developed a process to grow the majority of bacteria from the gut, the same way gynecologists culture microorganisms from a pap smear. The process was tricky, however, as many of these bacteria cannot survive when exposed to oxygen.
According to Hilary Browne of the Host-Microbiota Interactions Laboratory at the Wellcome Trust Sanger Institute, “…by developing a new process to isolate gastrointestinal bacteria, we were able to sequence their genomes to understand more about their biology. We can also store them for long periods of time making them available for further research.”

Tailor-Made Probiotics
A third of the gut microbiome is unique to every individual, and the research aims to produce tailor-made treatments using these specific beneficial bacteria from individual gut microbiomes. Dr. Sam Forster from the Sanger Institute and Hudson Institute of Medical Research in Australia says, “The extensive database of genomes we have generated from these bacteria is also essential for studying which bacteria are present or absent in people with gastrointestinal conditions. Now we can start to design mixtures of therapeutics candidates for use in these diseases.”
Researchers also found that a third of the microorganisms from a healthy person’s gut are capable of producing spores that can be airborne–implying that not only can people succumb to diseases from each other, but also acquire beneficial microrganisms.